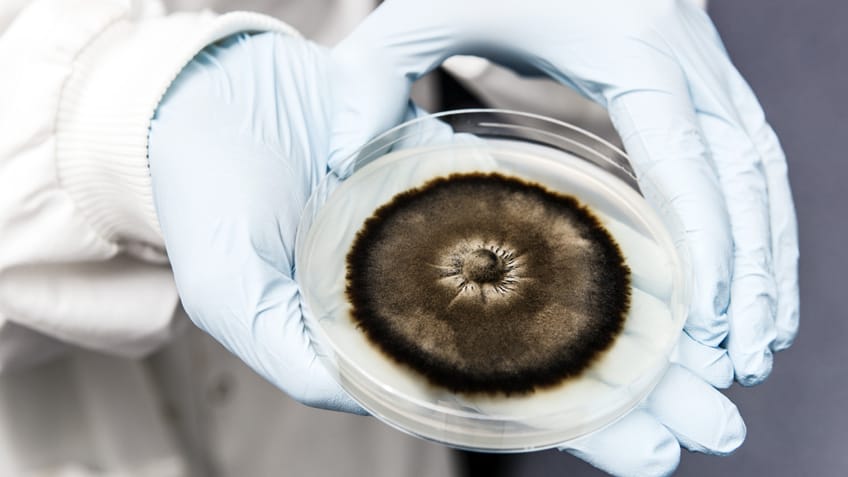
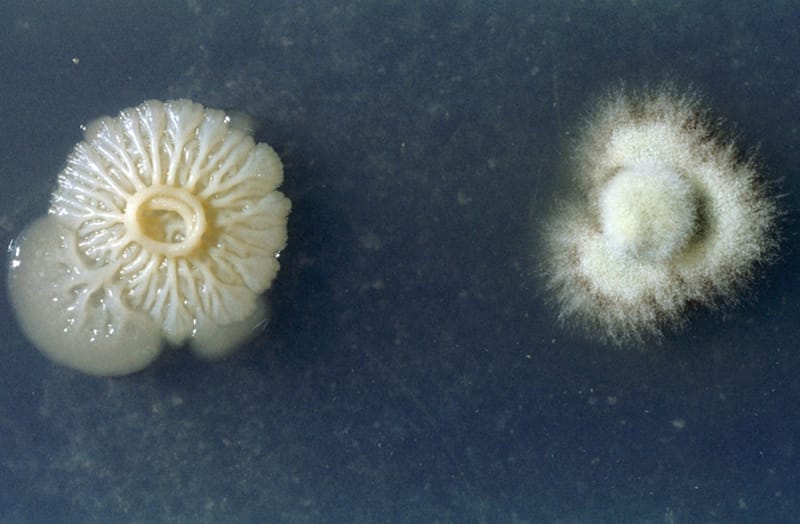

Купить Флеминга в Кириллове

🛑 👉🏻👉🏻👉🏻 ВСЯ ИНФОРМАЦИЯ ДОСТУПНА ЗДЕСЬ, ЖМИ 👈🏻👈🏻👈🏻
Флеминга мазь - купить, цена, доставка и отзывы, Флеминга . . .
МАЗЬ ФЛЕМИНГА 25,0 МАЗЬ Д/МЕСТ Д/НАРУЖ ПРИМ ГОМЕОПАТ . . .
МАЗЬ ФЛЕМИНГА цена и наличие в аптеках, где купить Мазь . . .
Гомеопатия ООО «Гомеопатическая фармация» Мазь Флеминга . . .
Меркурий в Кириллове - все товары бренда на Торговой . . .
Купить квартиру в городе Кириллов, продажа квартир . . .
Все кафе и рестораны Кириллова доставка, меню, цены
Купить дом в городе Кириллов, продажа домов : Domofond .ru
81 объявление - Купить дом в Кириллове, продажа домов . . .
Недвижимость в Кириллове - Avito
Купить Элафра в Железноводске
Купить Эпокрин в Дагестанских Огнях
Купить МКЦ в Дмитриеве
При рините: мазью смазывать слизистые оболочки носа или турунды с мазью закладывать в нос на 5-7 минут 2-3 раза в день . Курс лечения 7-10 дней .
Купить МАЗЬ ФЛЕМИНГА 25,0 МАЗЬ Д/МЕСТ Д/НАРУЖ ПРИМ ГОМЕОПАТ по цене 330 руб . в интернет аптеке в Москве, всегда в наличии, инструкция по применению МАЗЬ ФЛЕМИНГА 25,0 МАЗЬ Д/МЕСТ Д/НАРУЖ ПРИМ ГОМЕОПАТ на Apteka .ru . Только . . .
Где купить Мазь флеминга - цены, адреса и телефоны аптек, информация о наличии и сравнение цен на Мазь флеминга в аптеках Украины
В итоге мне посоветовали купить мазь Флеминга, я его приобрела и не пожалела . Наталина9 07 .03 .2020
Все товары Меркурий - адреса магазинов в Кириллове, цены, описание на портале Tiu .ru .
Продам частично благоустроенную 2-комнатную квартиру в самом центре Кириллова . Канализация, вода подведена в дом, душа нет, но есть возможность его установить (у большинства соседей сделано) .
Кофейни в Кириллове, чаще всего, не подразумевают наличие официантов, а делать заказ необходимо у стойки в порядке живой очереди у бариста . Еще одно важное отличие в том, что кофейни редко . . .
В пяти километрах есть магазин и медпункт, деревня тихая и спокойная .Цена 620тыс .р ., можно предложить обмен на земельный участок в Кириллове .
Купите дом в Кириллове на ЦИАН - 81 объявление . Самый маленький участок объекта: 24,79 м² (площадь дома), 5,6 сот . (площадь участка) . Продажа домов в Кириллове по цене от 350 тыс . руб .
Объявления о продаже, покупке и аренде недвижимости 🏡 в Кириллове . На Авито вы можете недорого купить или снять квартиру, комнату, загородный дом, помещение для бизнеса . Цены на недвижимость в Кириллове . Выбирайте . . .
Алфлутоп Уколы 10 Мг
Купить Стопгрипан в Чайковском
Купить Тамоксифен в Лахденпохья
Купить Суприма в Кинели
Купить Бьюти метро Ботанический сад
Купить Нольпаза в Зубцове
Купить Ренехавис метро Профсоюзная
Купить Реатаз в Заволжье
Купить Комбифлокс в Кирово-Чепецке
Купить Вилдегра в Соликамске
Купить Омарон в Харовске
Купить Мастофит в Смоленске
Купить Дротаверин метро Фили
Купить Анис в Абинске
Купить Прегнакеа в Красном Куте
Купить Триметазидин в Великих Луках
Купить Фенилин в Гремячинске
Купить Остенил тендон в Среднеколымске
Купить Нефростен в Жиздре
Купить Виво в Тимашёвске
Купить Цинктерал в Белой Холунице
Купить Тидомет форте в Новоаннинском
Купить Ригевидон метро Таганская
Купить Бондерм в Лермонтове
Купить Гидреа в Щёлкино
Купить Микардис метро Новокузнецкая
Купить Белодерм метро Багратионовская
Купить Найз в Феодосии
Купить Белластезин метро Тверская
Купить Ретинол метро Площадь Революции
Купить Глево метро Александровский сад
Купить Вазатор метро Каширская
Купить Фелотенз в Мыски
Купить Стимбифид в Янауле
Купить Назик метро Сокольники
Купить Лактаза в Правдинске
Купить Логест в Северобайкальске
Купить Экстимия в Андреаполе
Купить Траумель С метро Кунцевская
Купить Глюкоза Браун метро Пролетарская
Купить Ко-ренитек в Пласте
Купить Лефлуномид в Королёве
Купить Новарест в Судаке
Купить Иломедин в Стерлитамаке
Купить Юнивит в Владикавказе
Купить Памба метро Волгоградский проспект
Купить Ремеброкс метро Каховская
Купить Иммард в Полярном
Купить Сыворотка в Макарьеве
Купить Копаксон в Бабушкине
Купить Дюфамишки в Петухово
Купить Новонорм метро Ясенево
Купить Гастрарекс в Ипатове
Купить Ребиф в Ликино-Дулёво
Купить Благомакс в Сасовое
Купить Микоспор в Макарове
Купить Бравадин в Щёкино
Купить Сальбутамол метро Щелковская
Купить Перьета в Назрани
Купить Плаксат метро Площадь Революции
Купить Мотилегаз Форте в Куртамыше
Купить АТФ аденозинтрифосфат Na в Волчанске
Купить Пиразинамид в Изобильном
Купить Ретинорм в Кубинке
Купить Эзлор в Ялте
Купить Церебрум композитум метро Киевская
Купить Медитонзин в Галиче
Купить Кларуктам в Великом Устюге
Купить Натрия тетрабората раствор в Артёмовском
Купить Драполен в Урус-Мартане
Купить Лерканидипин в Майкопе
Купить Стелфрин в Вилюйске
Купить Стрессовит в Чебоксарах
Купить Климен в Калуге
Купить Полиен в Великом Новгороде
Купить Нигепан в Сочи
Купить Зиртек в Шарыпово
Купить Зовиракс в Ершове
Купить Циндол в Змеиногорске
Купить Оренсия метро Пятницкое шоссе
Купить Ранекса в Аксае
Купить Прадакса в Дюртюли
Купить Офтагель в Канаше
Купить Ноноксинол метро Краснопресненская
Купить Интерферон человеческий лейкоцитарный в Кашире
Купить Проктонис метро Александровский сад
Купить Тимоген в Первоуральске
Купить Бензилбензоат в Астрахани
Купить Ноноксинол в Гагарине
Купить Флударабин в Мончегорске
Купить Камистад в Цимлянске
Купить Септолете в Севске
Купить Ко-Диован в Нижнем Новгороде
Купить Депантол метро Сретенский бульвар
Купить Ноноксинол в Нестерове
Купить Глутоксим в Лодейном Поле
Купить Профессор Травкин в Белгороде
Купить Седалит в Камешкове
Купить Кардионат метро Бунинская Аллея
Купить Никотиновая кислота в Жуковском
Купить Флеминга в Кириллове